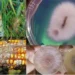
चीनले बनायो नयाँ भाइरस ‘फुसेरियम’, अमेरिकाले गर्‍यो खुलासा

पाटन (ललितपुर), २६ जेठः युवालाई रोजगारीसँग जोड्ने गरी दीर्घकालीन प्रभावकारी नीतिगत व्यवस्था गर्न ललितपुर महानगरलाई सङ्घीय सांसद र प्रदेशसभा सदस्यले सुझाव दिनुभएको छ ।
आगामी आर्थिक वर्ष २०८२÷८३ को नीति तथा कार्यक्रम तर्जुमा सम्बन्धमा सङ्घीय सांसद र प्रदेशसभा सदस्यसँगको छलफलमा ललितपुर क्षेत्र नं १ बाट प्रतिनिधित्व गर्ने नेपाली कांग्रेसका प्रतिनिधिसभा सदस्य उदयशम्शेर राणाले केन्द्रीय सरकारको बजेट साँघुरो हुँदै गएको र स्थानीय तहको बजेट बढ्दै गएको अवस्था महानगरभित्रको सडक व्यवस्थापनलाई बढी जोड दिन आग्रह गर्नुभयो ।
“चक्रपथ क्षेत्रमा फ्लाइओभर र अन्डरपास एकैपटक बनाउन सके १० वर्ष कुनै समस्या आउँदैन, केही समय समस्या होला, पछि राम्रो नतिजा आउँछ”, उहाँले भन्नुभयो । उहाँले महानगरको सुनाकोठी क्षेत्रको सडक व्यवस्थापनलाई ध्यान दिन आग्रह गर्नुभयो ।
“सुनाकोठीका स्थानीय जग्गा छाड्न तयार छन्, १८ घरलाई मुआब्जा दिइसकेका छौँ, बाँकीलाई ध्यान दिनुप¥यो, कान्तिलोकपथलाई व्यवस्थित गर्न सके वीरगञ्जसम्म पुग्न कठिनाइ हुँदैन, नख्खु करिडोरको व्यवस्थापनका लागि ध्यान दिनुप¥यो”, सांसद राणाले भन्नुभयो ।
ललितपुर क्षेत्र नं २ बाट प्रतिनिधित्व गर्ने नेपाल कम्युनिष्ट पार्टी (एमाले)का सांसद प्रेमबहादुर महर्जनले हस्तकलाको प्रवद्र्धन, युवालाई रोजगारी सिर्जना गर्ने र उद्योग व्यवसायमैत्री योजना आवश्यक रहेको भन्दै यसतर्फ ध्यान दिन आग्रह गर्नुभयो ।
“पुरातात्विक महत्वका घरहरूलाई संरक्षण गर्न ध्यान दिनुपर्नेछ, सामुदायिक विद्यालयको शिक्षा सुधारमा पनि अत्यन्तै ध्यान दिनुपर्ने आवश्यकता रहेको छ, निजीलाई भन्दा सामुदायिक विद्यालयलाई गुणस्तरीय बनाउन हामीले ध्यान दिनुपर्ने छ, फोहोर व्यवस्थापन, सम्पदा क्षेत्रको संरक्षणका साथै युवालाई रोजगारीसँगसँगै महानगरभित्रका उद्योग व्यवसायलाई प्रोत्साहन गर्नेगरी योजना तर्जुमा गर्न आग्रह छ,” उहाँले भन्नुभयो ।
उहाँले महानगरवासीले महसुस गर्नेगरी देखिने र सामाजिक रुपमा न्याय हुनेगरी बजेट व्यवस्थापन गर्न आग्रह गर्नुभयो । “सेवा प्रवाहमा जनताले महसुस हुनेगरी काम हुनुपर्छ, वर्तमान व्यवस्थालाई प्रोत्साहित गर्नेगरी नागरिकले महसुस गर्ने खालका योजना तर्जुमा आवश्यक छ, सांस्कृतिक सम्पदा र सार्वजनिक जग्गा संरक्षणका साथै अव्यवस्थित बसोबासीलाई पनि ध्यान दिएर योजना बन्नुपर्छ”, उहाँले भन्नुभयो । उहाँले विपद् व्यवस्थापनमा पूर्वतयारी गरेर आलोचना कम हुनेगरी काम गर्न आग्रह गर्दै अभौतिक सांस्कृतिक सम्पदाको जगेर्ना गर्ने काममा ध्यान दिएर काम गर्न आग्रह गर्नुभयो ।
राष्ट्रिय प्रजातन्त्र पार्टीबाट प्रतिनिधित्व गर्ने प्रतिनिधिसभा सदस्य रोशन कार्कीले सार्वजनिक जग्गाको संरक्षण गर्ने र सूचीकृत गर्नाका साथै सामुदायिक विद्यालयहरुको जग्गा र भौतिक संरचनालाई गलत प्रयोजनमा उपयोग हुन नदिन आग्रह गर्नुभयो । उहाँले महानगरभित्र खुल्ला सार्वजनिक क्षेत्रलाई संरक्षण गर्न र पर्यटनलाई प्रवद्र्धन गर्नेगरी योजना तर्जुमा गर्न आग्रह गर्नुभयो ।
बागमती प्रदेशसभा सदस्य रघुनाथ महर्जनले सडकको मापदण्डभित्र नयाँ संरचना निर्माण गर्नलाई रोक्नेमा ध्यान दिनुपर्ने, नख्खु करिडोरको मर्मतसम्भारमा ध्यान दिनुपर्ने र युवालाई रोजगारीको अवसर सिर्जना गर्न महानगरले ध्यान दिनुपर्ने सुझाव दिनुभयो । उहाँले ललितपुरको हस्तकला क्षेत्रलाई प्रवद्र्धन, हाट बजारको व्यवस्थापन, वातावरण संरक्षण, प्रदूषण न्यूनीकरण र खोलानालाको स्वच्छता कायम राख्दै संरक्षण गर्नेगरी नीतिगत सम्बोधन गर्न र बजेट तर्जुमा गर्न आग्रह गर्नुभयो ।
ललितपुर महानगरका प्रमुख चिरीबाबु महर्जनले जनप्रतिनिधि विषय विज्ञ नभएकाले सुझाव लिन सरोकारवाला र विज्ञसँग छलफल आयोजना गरेको बताउनभयो । “सबैका कुरा सुन्न फरक फरक क्षेत्रका विज्ञसँग छलफल राखेका हौँ, सङ्घीय सांसद तथा प्रदेशसभा सदस्यहरुबाट महत्वपूर्ण सुझाव आएको छ, प्राप्त सुझावलाई हामी समावेश गर्छौं,” उहाँले भन्नुभयो ।
उपप्रमुख तथा बजेट तर्जुमा समितिका संयोजक मञ्जली शाक्य बज्राचार्यले नीतिमा समावेश गर्ने विषयबारे छलफल गर्न कार्यक्रम आयोजना गरिएको बताउनुभयो । “नीति राम्रो भयो भने बजेट र कार्यक्रम राम्रो आउँछ, त्यसैले चरणबद्ध रुपमा कार्यक्रम राखेका हौँ,” उहाँले भन्नुभयो ।
प्रमुख प्रशासकीय अधिकृत रेखादास श्रेष्ठले प्रतिनिधिसभा, राष्ट्रियसभा र प्रदेशसभाका सदस्यबाट प्राप्त सुझावअनुसार महानगरले आर्थिक वर्ष २०८१÷८२ मा लागू गरेको वार्षिक योजना ८९ प्रतिशत कार्यान्वयन गर्न सफल भएको बताउनुभयो । उहाँले सेवा प्रवाहमा डिजिटल प्रणाली लागू गर्ने सन्दर्भमा महानगरले उल्लेखनीय उपलब्धि हासिल गरेको बताउँदै सङ्घीय सांसद र प्रदेश सदस्यको सुझावका आधारमा आगामी वर्षको नीति तथा कार्यक्रमलाई परिस्कृत बनाएर कार्यान्वयनमा लगिने जानकारी गराउनुभयो ।
श्रेष्ठले सहभागितामूलक नीति निर्माण गर्न विविधतापूर्ण समुदाय र क्षेत्रलाई समेटेर छलफल कार्यक्रम आयोजना गरेको धारणा व्यक्त गर्नुभयो । उहाँले अघिल्लो आर्थिक वर्षका ३२४ मध्ये ८९ प्रतिशत नीति सम्बोधन गर्न महानगर सफल भएको जानकारी दिनुभयो ।